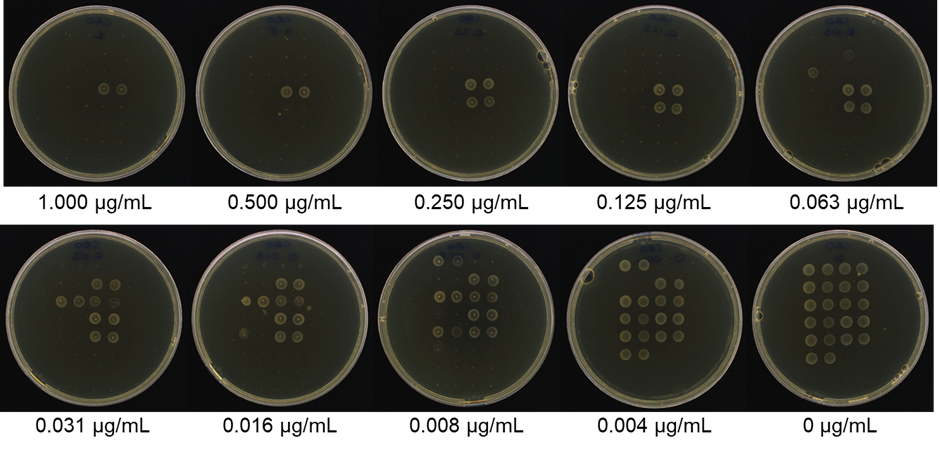

The rise of drug-resistant Neisseria gonorrhoeae is becoming a significant global health concern. With increasing incidences of ceftriaxone-resistant strains, treating gonorrhea has become progressively challenging. If left untreated, gonorrhea can lead to severe complications such as pelvic inflammatory disease, infertility, ectopic pregnancies, and a heightened risk for the acquisition and transmission of HIV. According to the World Health Organization (WHO), there were 82 million new cases of gonorrhea globally in 2020. This alarming statistic underscores the urgent need for novel antibiotic solutions.
Evotec's Comprehensive Approach to Drug Discovery
Recognizing the urgency, Evotec has developed a comprehensive platform dedicated to discovering new antibiotics to combat drug-resistant N. gonorrhoeae. Their approach integrates advanced in vitro and in vivo profiling techniques to identify promising drug candidates efficiently. With a collection of over 70 isolates of N. gonorrhoeae, including WHO gonococcal reference strains and clinical isolates from the CDC and FDA, Evotec is well-equipped to tackle this pressing issue.
Advanced In Vitro Profiling Techniques
Evotec employs a robust set of in vitro
profiling techniques to evaluate the effectiveness of potential antibiotics, including the assessment of the risk of development of resistance. One of the key methods used is the minimal inhibitory concentration (MIC) assay, which determines the lowest concentration of an antimicrobial that can inhibit bacterial growth. By using CLSI-based protocols and liquid media, Evotec ensures accurate and reliable results. This in vitro profiling is crucial for identifying compounds that show potential in effectively combating N. gonorrhoeae.
In vitro profiling by MIC assays – CLSI based protocol
Figure 1 AD-MIC Celftrixone
In Vivo Profiling Methods
In addition to in vitro techniques, Evotec utilizes in vivo profiling methods to further validate the efficacy of potential drug candidates. Their mouse model of vaginal infection is a pivotal component of this process. By preconditioning BALB/c mice and establishing an infection with N. gonorrhoeae FA1090, researchers can assess the impact of different antibiotic treatments. For instance, a single administration of ceftriaxone at 5 mg/kg significantly reduced bacterial burden in both vaginal lavage fluid and tissue, demonstrating the potential of this approach.
Significance of Bacterial Cytological Profiling
Another innovative technique employed is bacterial cytological profiling (BCP). This method involves treating N. gonorrhoeae with different classes of antibiotics and analyzing their specific antibacterial mechanisms of action. By using dyes such as FM 4-64, DAPI, and Sytox Green, researchers can determine the combined profile of cell shape, membrane permeability, and DNA integrity. This detailed analysis provides valuable insights into how new antibiotics can target and disrupt bacterial cells.
N. gonorrhoeae ATCC 700825 (colistin-sensitive) cytological profiling
Promising New Drug Candidates on the Horizon
By combining advanced in vitro and in vivo profiling techniques with cutting-edge bacterial cytological profiling, we can support identifying new antibiotics. As resistance continues to outpace current treatments, collaborative innovation is essential. Evotec’s platform is not just a tool, it’s an invitation to partners across academia and the biotech and the Pharma industry to accelerate the next generation of gonorrhea therapeutics.